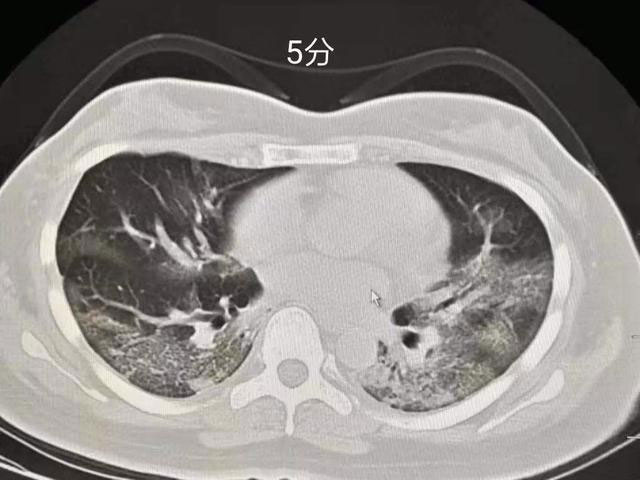
˫Ĥ෢Ƭ״ĥܶӰ߽ɶڣڣݱΪƬʵաά2

新型冠状病毒肺炎肺部CT表现的5个特点
- 2020-02-10 08:13
- 湘雅医院
- 医学影像科
临床上确诊新冠肺炎依据是病毒核酸检测阳性。那么,检测阴性就排除新型冠状病毒感染了吗?
近日,有一例患者 4 次病毒核酸检查都是阴性,直到第5次才正式确诊,而这期间,他的肺部CT一直符合典型的病毒性肺炎表现。
相比于检测周期长,存在假阴性的核酸检测,通过肺部CT是否更能做到早诊断早治疗呢?

根据国家卫健委发布的最新版《新型冠状病毒感染的肺炎诊疗方案(试行第五版)》,确诊病例需要病原学检查,但临床诊断基本靠影像学。
疑似病例:结合流行病学和临床表现(发热和(或)呼吸道症状、影像学、血常规);
确诊病例:病原学证据。
临床确诊病例(湖北省内):疑似病例具有肺炎影像学特征者。
因此,CT 影像作为新冠肺炎临床诊断的重要依据,在早期快速识别可疑患者中发挥重要价值。
那么,拿到患者的肺部CT,如何准确做出预判呢?
湘雅医院放射科熊曾副主任医师结合最新临床病例,总结出新型冠状病毒肺炎CT影像学5大特点:
1. 部位特征
胸膜下,由单一病灶迅速扩展至双肺;

2. 基本病变
磨玻璃影,伴有间质增厚,血管增粗,可见铺路石征;

3. 受累情况
未受累的肺影像表现正常;

4. 少见改变
少数出现结节伴晕征,胸水;

5. 罕见表现
支气管改变,淋巴结增大不多见。

相关阅读:如何在CT上对2019-nCoV肺炎进行评分
来源: 华夏影像诊断中心
新型冠状病毒核酸检测能力不足,不能满足所有疑似患者的需要,并存在一定的假阴性,因此提升CT在新型冠状病毒感染性肺炎诊断中的地位显得尤为重要。
受到诊治一线医生及影像同行的启发,2019新型冠状病毒(2019-nCoV)感染肺炎CT评分的初步构想如下(本人原创,仅供同行参考):
0分:肺部CT无异常征象。
1分:少许钙化,肺大泡,小结节等。
临床意义:与新型冠状病毒(2019-nCoV)感染无相关性。
2分:广泛肺气肿,肺纤维化,肺恶性肿瘤等。
临床意义:患者可能更易感染新型冠状病毒,或者感染后更容易发展为重症。
3分:局限的叶段病变,叶段小斑片影或多发小结节,提示肺部感染性病变(细菌或结核或其它病毒感染,也可能难于鉴别),有较小的新型冠状病毒感染的可能性。

临床意义:居家隔离和社区隔离,针对性抗菌或抗结核等治疗后复查;如治疗无效,核酸检测判断是否新型冠状病毒(2019-nCoV)感染。
4分:单个叶段的中心实变周围磨玻璃密度影,或双肺多发的小斑片或磨玻璃密度影,形态各异,提示肺部感染性病变,有较大的新型冠状病毒感染可能性。


临床意义:医院隔离治疗,申请核酸检测,阳性可确诊2019-nCoV感染。
5分:双肺胸膜下区多发斑片状磨玻璃密度影,边界清楚,可短期(几天内)演变为大片实变或者逐渐吸收、纤维化,强烈提示新型冠状病毒感染性肺炎。

临床意义:无论核酸检测是否阳性,依照2019新型冠状病毒(2019-nCoV)感染肺炎治疗,传染病病房隔离。亲密接触者隔离观察。
下图为评分图解






